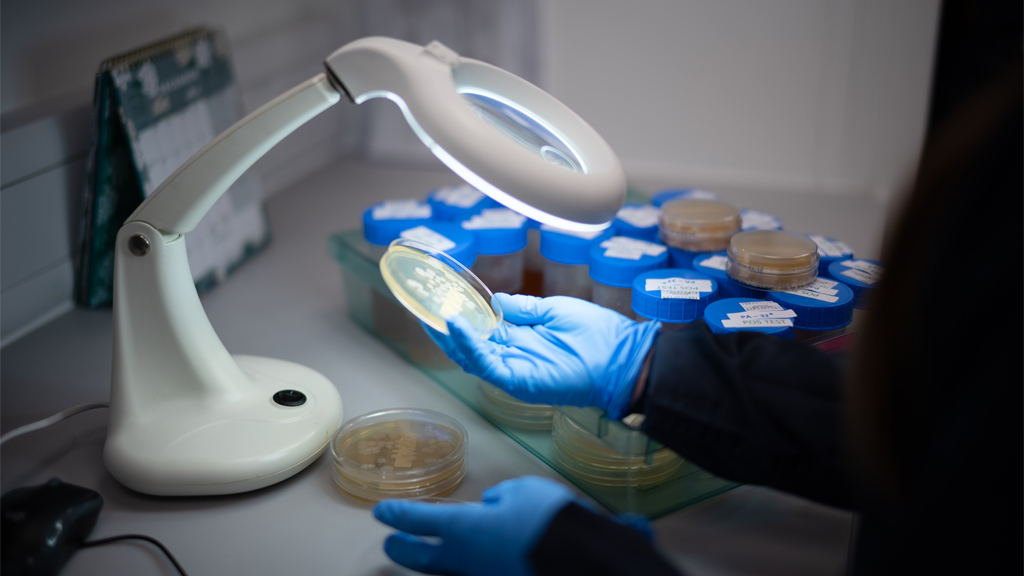
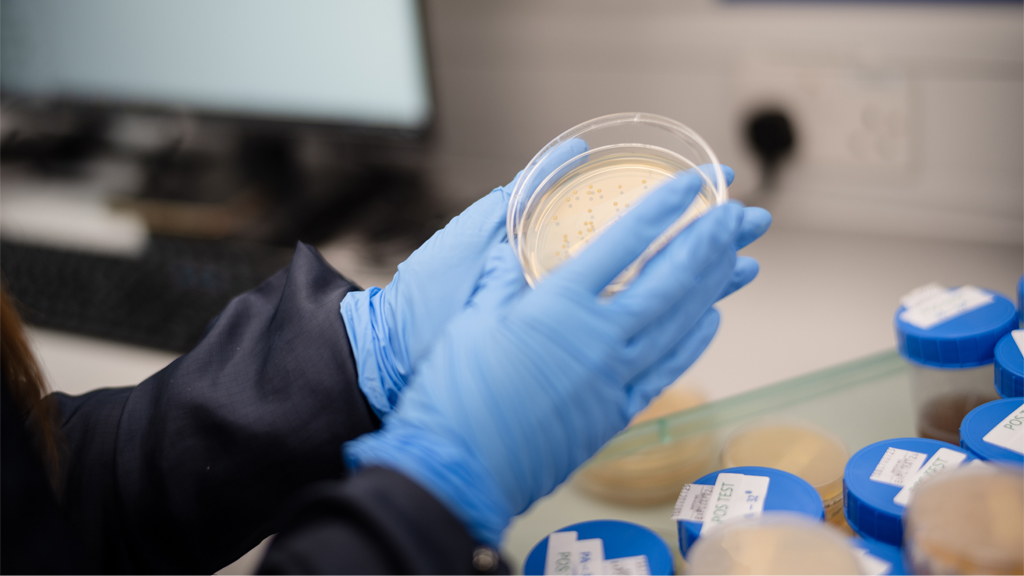
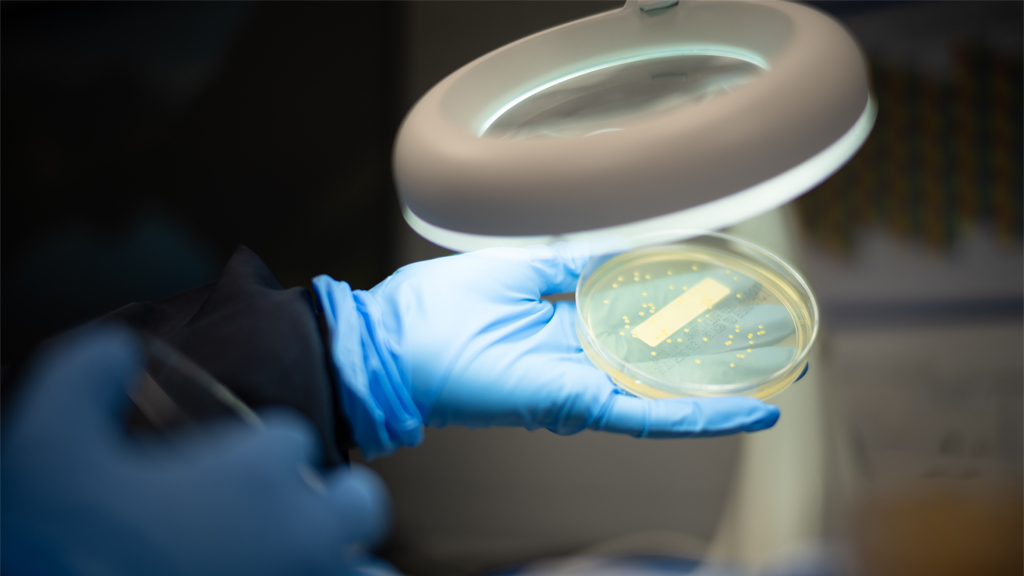

Modern manufacturing environments demand microbiology systems that provide confidence, clarity, and control. As products, processes, and regulatory expectations grow more complex, contamination control risk increases – and teams require a microbiology function that is structured, predictable, and tightly aligned to quality and operations.
Our approach brings the same discipline and governance found in high performing programme environments into the microbiology space, ensuring that monitoring, utilities, release testing, ID, and investigations operate with consistency and transparency.